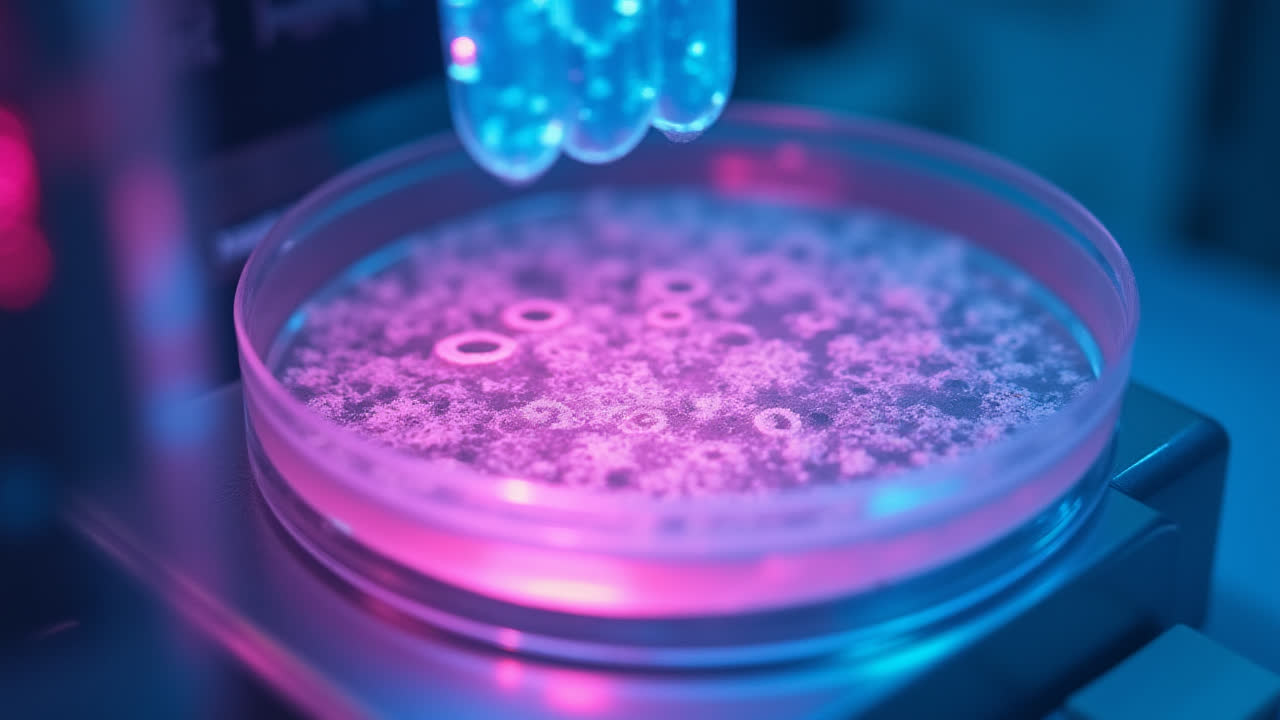
How Gel Electrophoresis Separates DNA Fragments: A Complete Guide

Epic vs Epoch: Understanding the Key Differences | English Grammar Guide

Epic vs Epoch: Understanding the Key Differences in English
Have you ever found yourself confused between epic and epoch? You're not alone! These two words sound remarkably similar when spoken aloud, yet they carry completely different meanings. As someone who's spent countless hours explaining this difference to English learners, I can tell you that this confusion is more common than you'd think.
What is an Epic?
Epic is both a noun and an adjective, which makes it a versatile word in our language. As a noun, an epic refers to a long narrative poem that tells the story of heroic deeds and adventures performed by legendary figures. You know those massive stories about heroes conquering dragons or sailing across vast seas? Those are epics!
When Beowulf faced that terrifying dragon in the ancient English poem, that was an epic tale. Speaking of which, using epic as an adjective has become quite trendy in casual conversation. Nowadays, you might hear someone say "That concert was epic!" meaning it was absolutely amazing or impressive.
But let's get back to literature for a moment. Some famous epics include:
- Homer's "The Iliad" and "The Odyssey"
- Virgil's "The Aeneid"
- John Milton's "Paradise Lost"
- The ancient English poem "Beowulf"
What is an Epoch?
An epoch, on the other hand, is a period of time that's characterized by particular events or developments. Think of it as a chapter in history where specific things happened. The Victorian epoch, for instance, was known for its distinct social values and technological advancements.
In more technical fields, the word takes on specialized meanings. Geologists use it to describe a smaller division of geological time, while astronomers use it as a reference point for celestial measurements. Here's something interesting – an epoch in geology is subdivided into ages, but that's getting pretty technical, isn't it?
Think of historical epochs like these:
- The Renaissance epoch
- The Industrial Revolution epoch
- The Digital epoch we're living in now
- The Elizabethan epoch
The Great Comparison: Epic vs Epoch
| Feature | Epic | Epoch |
|---|---|---|
| Definition | Long narrative poem about heroic deeds | A particular period in history or time |
| Part of Speech | Noun and adjective | Noun only |
| Primary Field | Literature | History, geology, astronomy |
| Example Usage | "The epic of Gilgamesh" or "an epic battle" | "The Victorian epoch" or "a new epoch in space travel" |
| Related Words | Heroic, legendary, grand | Period, era, age |
| Adjective Form | Can be used as adjective | Cannot be used as adjective |
| Informal Usage | Slang for "awesome" or "impressive" | Not used informally |
| Scientific Applications | None | Geology: subdivision of period; Astronomy: reference date |
Common Usage Mistakes to Avoid
I've noticed that people often mix these words up in writing, particularly in academic contexts. It's easy to understand why – they're both five-letter words starting with 'ep' and sounding quite similar when said quickly. Here's a simple trick I teach my students: think "epic for stories, epoch for times." Both start with 'e', and one tells epic tales while the other marks historic time periods.
Sometimes I catch myself using epic informally, like when I say "That movie was epic!" But I'd never say something was epoch – that would be completely wrong. It's funny how language evolves, isn't it?
Real-World Examples
Let me share a story that perfectly illustrates the difference. Last year, I visited a museum that displayed an ancient manuscript of the Beowulf epic. The curator explained that this epic poem was written during the Anglo-Saxon epoch of English history. See how one describes the story (epic) while the other describes the time period (epoch)?
In modern contexts, you might hear someone say: "The space exploration epoch began with Sputnik." But when referring to movies or books, we say: "Star Wars is an epic space saga." The distinction becomes clearer with practice, trust me!
Historical Context
Understanding these words in their historical context helps cement their meanings. During the Romantic epoch of literature, many epics were written that celebrated nature and individual heroism. It's like having a conversation about art during a specific time period – the epoch provides the backdrop while the epics are the artworks themselves.
The etymology is fascinating too. Epic comes from the Greek "epikos," meaning "a word, story, poem," while epoch comes from "epoche," meaning "a stoppage, fixed point of time." Even their origins tell different stories!
Making the Distinction Stick
Here's a memory trick that works well: imagine an epic hero (think Superman or Wonder Woman) fighting across the pages of history through different epochs. The hero represents the epic – they're performing grand deeds. The time periods they travel through? Those are the epochs.
Remember, when you're reading about great literary works, you're dealing with epics. When historians discuss different periods of time, they're talking about epochs. It's as simple as stories versus time periods.
Frequently Asked Questions
What are some examples of famous epics in literature?
Some of the most celebrated epics include Homer's "The Iliad" and "The Odyssey," which tell stories of the Trojan War and Odysseus's journey home. "Beowulf" stands as one of the earliest English epics, while John Milton's "Paradise Lost" is considered one of the greatest epic poems in the English language. These works all share common elements: heroic protagonists, grand adventures, and significant cultural impact.
How do scientists use the term "epoch" in their fields?
In geology, an epoch is a subdivision of a geological period, representing millions of years of Earth's history. For example, the Paleocene epoch followed the extinction of dinosaurs. In astronomy, an epoch serves as a specific date for reference when describing celestial positions, such as "epoch 2000.0" which corresponds to January 1, 2000. These scientific uses show how the term denotes specific time periods in various contexts.
Can "epic" and "epoch" ever be used together in the same context?
Absolutely! You might say, "During the Elizabethan epoch, Shakespeare wrote many epic plays." Here, one word describes the time period (epoch) while the other describes the nature of the literary works (epic). This combination often appears in historical and literary discussions where we examine great works within their historical timeframes.